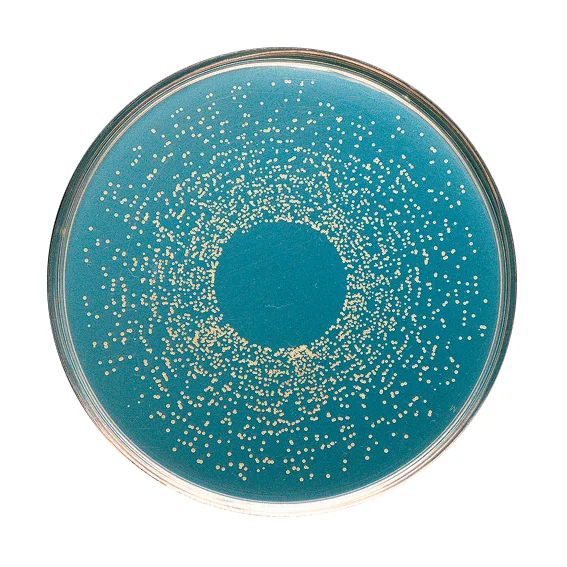

AS1 provides our clients with the necessary consumables and accessories to accomplish your necessary laboratory tasks.
Street Address
Rotorua
64 29 479 3733
AS1 provides our clients with the necessary consumables and accessories to accomplish your necessary laboratory tasks.

Sales & Marketing
Anna Wilson
Email - annawilson@as1.co.nz
Phone - 029 479 3733
Managing Director
Alan White
Email - alanwhite@as1.co.nz
Phone - 06 353 8200
